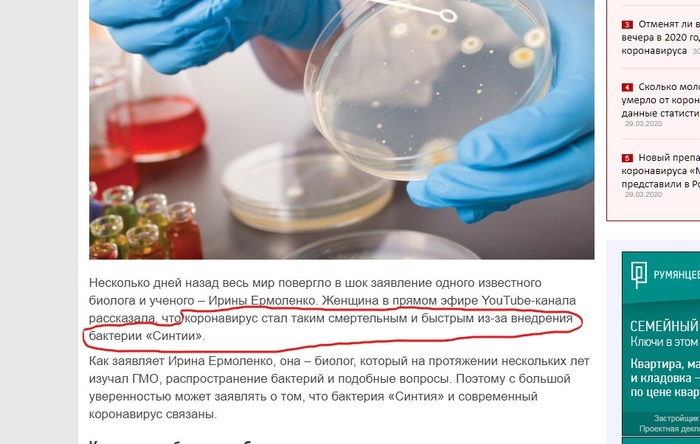

Что за зверь этот д-димер
Все чаще гематологи стали сталкиваться с жалобами пациентов на «густую кровь» или «жидкую кровь» . И честно признаюсь- это, как постоянно сверлящий за стенкой сосед или противный скрип половицы , сильно раздражает . Система гемостаза очень сложна и многогранна. В жидком состояние нашу кровь поддерживает фибринолитическое и антикоагулянтное звенья гемостаза, а когда нужно залатать ранку или остановить кровотечение , то на помощь спешат сосудисто-тромбоцитарное и коагуляционное звенья и запускаются сложные множественные коагуляционные каскады, в которых задействованы десятки разных факторов.
Однозначно, по анализам коагулограммы просто невозможно сделать вывод о «жидкой» или «густой» крови . Все не так просто. Порой даже опытные гематологи при видя результатов анализов и общаясь с пациентом нервно почесывают затылок. В помощь докторам идет подробный сбор жалоб и анамнеза пациента, корнями уходящий в детство и мучительный допрос о ближайших родственниках. Так же фотография коагулограммы не заменит грамотного осмотра пациента ,высыпаний на теле ,асимметрии конечностей ,гематом, петехий и тд…
Поэтому если вам на приеме, или по телемеду кто то сказал «у вас густая кровь» или «у вас слишком жидкая кровь», нужно ее сделать гуще - бегите, бегите к другому врачу.
Мы не должны лечить анализы, должны лечить пациента.
Не всегда изменения в коагулограмме требуют дополнительных обследований и еще реже они требуют лечения. Иногда просто достаточно включить логику.
На примере д-димера ,так полюбившемуся пациентам и некоторым докторам в последнее время, я попробую рассказать, как надо и как не надо реагировать на показатели гемостаза .
D-димеры – фрагменты молекулы фибрина, образующиеся при его распаде. Такое название они получили из-за того, что содержат два соединяющихся D-фрагмента белка фибриногена.
Фибрин- составляет основу сгустка.
Повышенный уровень D-димеров в крови указывает на повышенную внутрисосудистую коагуляцию или фибринолиз. Он не позволяет судить о локализации тромба, а лишь может указать на возможное его наличие в сосудистом русле .
Зато нормальный уровень д-димера в плазме крови может использоваться для исключения тромбоза любой локализации.
Итак ,зачем нам нужен д димер ?
Существует всего одно показание для сдачи д-димера : подтверждение или опровержение тромбоза или ДВС ( диссеминированного внутрисосудистого свертывания крови).
Как надо :
Есть подозрение на тромбоз ( при сборе жалоб и осмотре пациента )- назначаем коагулограмму с д-димером. Если уровень д-димера высокий - ищем тромбоз инструментально. А уже при обнаружении тромба назначается антикоагулянтная терапия. При нормальном уровне д-димера- вероятность тромбоза стремиться к 0 .Так зачем лечить то, что не существует ?
Чрезмерно высокие цифры д-димеров ( более чем в 10 раз выше ) у пациентов действительно были ассоциированы с тромбозами и ТЭЛА, тяжелой онкологией, сепсисом, большой полостной операцией. Но эти уже были госпитализированы в стационар с какими либо жалобами или диагнозом.
Как не надо :
На практике мы имеем совершенно иное : «сказали сдать на всякий случай», «бесплатно было, что ж не сдать то», «входило в панель коагулограммы» и тд.
И вот у нас нет ни жалоб, ни каких отдаленных подозрений на тромбоз и мы получаем ВЫСОКИЙ д-димер. И начинается круговорот пациента в природе системы ОМС, ДМС, коммерции : множество дополнительных анализов и УЗИ ,стресс ,бессонница, депрессия. «У меня густая кровь, где то тромб».
Внимание ! Обнаружение высокого уровня д-димера НЕ МОЖЕТ расцениваться как 100% случившийся тромбоз или вот-вот образующийся тромб .
Существуют и другие неспецефические причины повышения уровня д-димера:
-гиповолемия( недостаточное потребление жидкости, большая потеря жидкости и неграмотное ее восполнение , например рвота, диарея )
- преаналитическая ошибка (перед сдачей крови ели много жирного, пили алкоголь и тд), а так же нарушение хранения и транспортировки биоматериала, ошибка лаборатории
-продолжающимся или недавно закончившимся кровотечении ( ЖКТ, геморроидального и тд)
-после травм и операций ( в том числе наличие средних и крупных гематом)
- воспалительные заболевания ( острое или обострение хронического)
-онкологические заболевания
-аутоиммунные заболевания ( СКВ и тд)
-повышение Холестерина и дислипидемия
-БЕРЕМЕННОСТЬ !!! ( В беременность чаще повышаются д-димеры, чем остаются в нормальном диапазоне. И препараты мы назначаем лишь тем пациенткам, у кого риск ВТЭО(венозных тромбоэмболических осложнений ) высокий. Препараты назначаются с целью профилактики тромбообразования, а не его лечения
- прием пероральных оральных контрацептивов или гормональной терапии ( В том числе при использовании ВРТ. Нет достоверных данных взаимосвязи высокого уровня д-димеров и неудач ЭКО или влияния на исход беременности )
-Д-димеры повышаются с возрастом и после 60ти лет могут быть выше в 2-4 раза.
Что делать, если вы все же сдали без показаний уровень д-димера и он пришел высокий ?
Если у вас нет жалоб и клинических проявлений - НЕ ПАНИКОВАТЬ !!!
- Скорректировать питьевой режим (30-40мл на 1 кг массы тела )
-Скорректировать питание ( ограничить и при возможности полностью исключить употребление жирной и жаренной пищи , особенно накануне сдачи крови )
- Кровь пересдать через 1-2 недели утром натощак ( желательно до 9.00 и не забыть выпить 1-2 стакана воды за пару часов до исследования )
- При появлении симптомов (боли в конечностях, сильное сдавление в груди и не мотивируемая одышка, стойкий ассиметричный отек и багрово-синюшний цвет конечностей и тд ) консультация флеболога/ангиохирурга и гематолога
При возникновении жалоб или сомнениях обращайтесь на прием к врачу